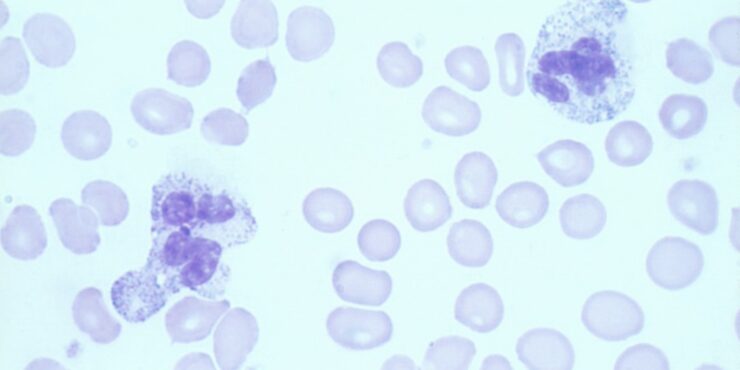

Kaposiform hemangioendothelioma =بطانوم وعائي دموي يشبه كابوزي
Kaposiform hemangioendothelioma =بطانوم وعائي دموي يشبه كابوزي OLYMPUS DIGITAL CAMERA OLYMPUS DIGITAL CAMERA OLYMPUS DIGITAL CAMERA Kaposiform Hemangioendothelioma KHE is a rare vascular tumor that has usually been reported in association with KMP. It may be present at birth or develop in early childhood. Rare adult cases have been reported. It may present as […]
Read More